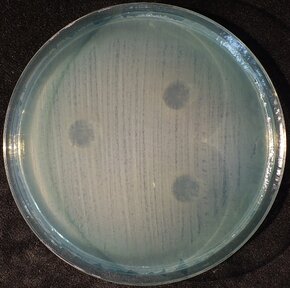
2 Pa_PL formuła.JPG

Innowacyjny środek zwalczający antybiotykooporne bakterie Pseudomonas aeruginosa (pałeczki ropy błękitnej), oparty na synergii naftochinonu i nanocząsteczek srebra, uzyskał ochronę patentową Urzędu Patentowego RP. Wynalazek został opracowany przez naukowczynie z Międzyuczelnianego Wydziału Biotechnologii UG i GUMed, Wydziału Chemii UG i Wydziału Chemicznego PG.



Zakażenia wywoływane przez pałeczkę ropy błękitnej (Pseudomonas aeruginosa) stanowią poważne wyzwanie dla współczesnej medycyny ze względu na wysoki stopień oporności tej bakterii na antybiotyki oraz jej znaczącą wirulencję. Pałeczka ropy błękitnej jest patogenem oportunistycznym, co oznacza, że występuje w środowisku oraz u człowieka, nie wywołując choroby, ale staje się groźna, gdy układ odpornościowy ulega osłabieniu, np. u pacjentów z chorobami przewlekłymi, osób starszych czy pacjentów z ranami chronicznymi.
Interdyscyplinarny zespół badaczek z Uniwersytetu Gdańskiego oraz Politechniki Gdańskiej opracował skuteczny preparat na bazie nanocząstek srebra i naftochinonu zwalczający pałeczkę ropy błękitnej poprzez hamowanie wzrostu i aktywne zabijanie komórek tego patogenu.
To kolejny, siódmy już patent na innowacyjne środki antybakteryjne zwalczające zakażenia pałeczką ropy błękitnej, który Urząd Patentowy RP przyznał dr Marcie Krychowiak-Maśnickiej i współwykonawcom. Nowo przyznany patent jest wynikiem współpracy interdyscyplinarnego zespołu naukowczyń, w którego skład wchodzą: dr Marta Krychowiak-Maśnicka (kierownik projektu) i prof. dr hab. Aleksandra Królicka z Zakładu Badania Związków Biologicznie Czynnych Międzyuczelnianego Wydziału Biotechnologii UG i GUMed, dr Aleksandra Bielicka-Giełdoń z Wydziału Chemii Uniwersytetu GDańskiego i dr Ewa Paluszkiewicz z Wydziału Chemicznego Politechniki Gdańskiej.
- Nasz preparat wykorzystuje zjawisko synergii srebra i naftochinonów, tj. wzajemnego zwiększania aktywności przeciwbakteryjnej tych dwóch czynników. Dzięki zjawisku synergii bardzo niskie dawki srebra i naftochinonu, które nie wykazują aktywności przeciwbakteryjnej gdy stosuje się oddzielnie, wykazują silne działanie bakteriobójcze po połączeniu, skutecznie zwalczając bakterie - tłumaczy dr Marta Krychowiak-Maśnicka. - Zastosowanie synergistycznych połączeń ma kluczowe znaczenie dla ograniczania wykształcania oporności przez bakterie, a tym samym przedłużania przydatności danej substancji w terapiach infekcji bakteryjnych. W preparacie wykorzystywane są nanocząstki srebra stanowiące innowacyjną i mniej toksyczną alternatywę dla soli srebra.
Prace nad wykorzystaniem zjawiska synergii do zwiększania efektywności srebra w zwalczaniu patogenów bakteryjnych są kontynuowane przez dr Martę Krychowiak-Maśnicką, a ich rezultaty zostaną wkrótce opublikowane.
- Aktualnie badania koncentrują się na pogłębieniu zrozumienia mechanizmu zjawiska synergii oraz na poszukiwaniu partnera biznesowego zainteresowanego praktycznym wykorzystaniem wyników naszych badań - dodaje naukowczyni.
Proces zabezpieczenia praw własności intelektualnej wynalazku został przeprowadzony przy wsparciu zespołu specjalistów Centrum Transferu Technologii UG, kierowanego przez Dyrektorkę Katarzynę Gronowską.